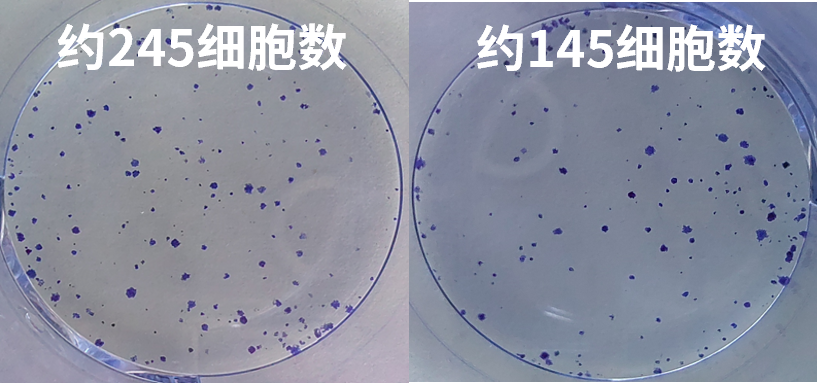

siRNA常规为化学合成的21~23nt的双链小分子RNA,通过特异性调控基因转录后的沉默过程,被广泛应用于生物体RNA干扰(RNAi)研究是研究基因功能的重要工具,金唯智有着丰富的siRNA设计与合成服务以及下游细胞功能实验经验。

| 服务 | 周期 | 交付 | 备注 |
|---|---|---|---|
| siRNA合成 | 最快5个工作日(5-10BD) | 2 OD/单条siRNA | / |
| siRNA(3保1)设计与合成 | 2 OD×3条目的siRNA; 1 OD×3对照siRNA |
保1针对人,大、小鼠 | |
| 定制化修饰siRNA合成 | 2 OD/单条siRNA | 如荧光、2'F、OMe、GalNAc等修饰,具体咨询 | |
| siRNA验证与细胞功能实验 | 咨询 | 咨询 | 如siRNA转染及效率检测; 如细胞克隆形成、增殖、迁移、凋亡等 |
注:2OD为起始交付规格,其他规格请咨询; siRNA默认交付为退火后的双链,3’ 端2个垂悬保护碱基dTdT等
JHH7细胞,siRNA细胞转染、mRNA水平验证及功能水平检测(克隆形成)

NC-FAM 转染24h荧光/白光

qPCR检测
NC-siRNA
GOI-siRNA